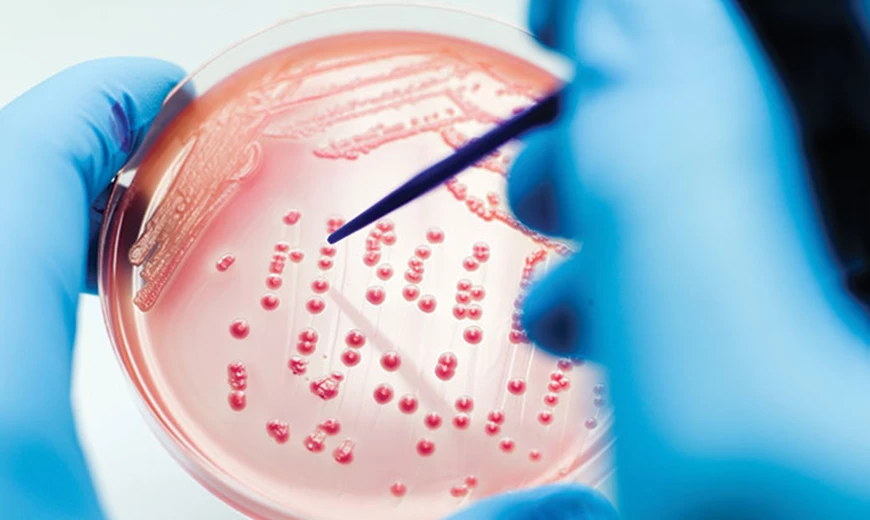
Laborprobe  Hautpilz lässt sich durch einen Arzt feststellen

Hautpilz
Ungeliebter „Mitbewohner“ unseres Organismus
Sie gehören zu unseren stetigen "Mitbewohnern": Darm- und Hautpilze. Eine Vielzahl der unterschiedlichsten Pilze auf der Haut siedelt unbemerkt auf der Hornschicht oder in den Schleimhäuten unseres Körpers. Das ist völlig normal und meistens kein Grund zur Beunruhigung. Wenn jedoch die Körperabwehr oder Hautbarriere geschwächt sind, kann Hautpilz schwerwiegende Infektionen auslösen.
Wie kommt es zu Hautpilz?

Pilzinfektionen mögen es gerne warm und feucht. Solche Bedingungen herrschen zum Beispiel in schlecht durchlüfteten Schuhen, unter dicht schließenden Höschenwindeln oder in Hautfalten. Schweiß oder andere Körperflüssigkeiten trocknen dann nicht richtig ab und bereiten Hautpilz einen idealen Nährboden. Ist die Körperabwehr dann noch angeschlagen, kommt es schnell zu einer Pilzerkrankung mit juckendem, gerötetem und brennendem Ausschlag und häufig cremigen Absonderungen.
Richtige Behandlung bei Hautpilz
Die Behandlung von Hautpilz hängt von der Art des Pilzes und dem spezifischen Auslöser ab. Häufig lässt sich z. B. eine Hefepilzerkrankung nach eindeutiger Diagnose gut behandeln: Zum Beispiel durch Multilind® Heilsalbe aus der Apotheke. Multilind® enthält eine besondere Wirkstoffkombination aus dem bewährten Antipilzwirkstoff Nystatin und entzündungshemmend wirkenden Zinkoxid.
Weitere interessante Artikel

Multilind® Heilsalbe
Die Kombination aus Nystatin & Zinkoxid lindert den Juckreiz und hemmt die Entzündung betroffener Hautstellen.